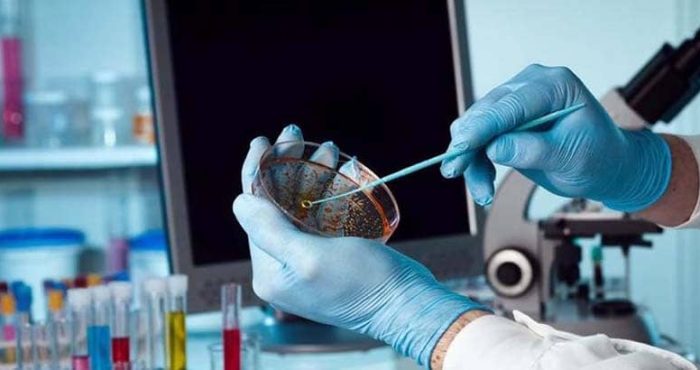
agroanalysesmaroc

Description
Agro Analyses Maroc, Recherche et essais, Rabat
– AgroAnalyses Maroc est un laboratoire d’Analyses Agroalimentaires, Privé et Indépendant, Accrédité NM ISO 17025 v 2018 et Agréé par l’ONSSA
– Le laboratoire AgroAnalyses Maroc propose à ses clients et partenaires des prestations analytiques Fiables, Rapides et Confidentielles :
1. Analyses Microbiologiques et Physico-Chimiques des denrées alimentaires
2. Analyses et contrôles des Aliments à différentes étapes de transformation depuis la matière première jusqu’aux produits finis
3. Analyses microbiologiques et physico chimiques des Eaux (potables, brutes, usées, piscines, process…)
4. Analyses de l’Environnement (surfaces, Air, Eaux…)
5. Accompagnement des industries agroalimentaires dans leurs démarches d’assurance qualité : Assistance, Conseil et Audit.
6. Formation en Hygiène et Sécurité Sanitaire.
• Le Laboratoire AgroAnalyses Maroc créé et dirigé par le Pr. My. Abderrahmane ALAOUI, dispose d’une équipe professionnelle stable, multidisciplinaire, formée et qualifiée.
• AgroAnalyses Maroc vous propose des Résultats Fiables grâce aux Contrôles Qualité Externes (CQE) mais aussi aux nombreux Contrôles Qualité Internes (CQI).
• AgroAnalyses Maroc vous propose des Résultats Rapides : Détection des Salmonelles en 48 h (si détection négative)
• AgroAnalyses Maroc participe à de nombreuses campagnes d’essais inter laboratoires aussi bien internationales que nationales : RAEMA, AGLAE, LGC, INRH, …
• Les cadres d’AgroAnalyses Maroc participent régulièrement aux commissions de normalisation.Clients et Partenaires de AgroAnalysesMarocLe portefeuille client est composé d’un panel de type diversifié :
– Institutionnels : SV ONSSA, Administrations Publiques, …
– Industriels Agro-Alimentaires
– Hôteliers
– Restauration collective, Catering
– Grandes et Moyennes Surfaces
– Professionnels des Métiers de Bouche : Restaurateurs, Traiteurs, Bouchers, Poissonnerie, Boyauderie, Boulangerie, Pâtisserie, Glacier,…
– Les établissements de santé, Les Universités, Les Ecoles
– Cabinet de Conseil et d’Ingénierie
– Club de sport
– Coopératives, Associations
– STEP (stations d’épuration des eaux)
– Particuliers